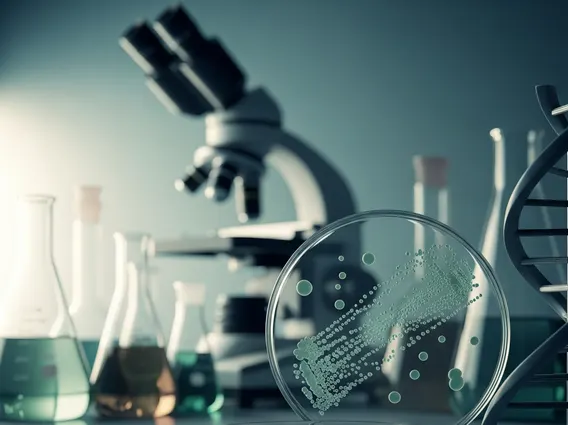

Flagyl
Flagyl is a widely recognized antibiotic and antiprotozoal medication used to treat a variety of infections caused by susceptible bacteria and parasites. It is a crucial medication in clinical settings for addressing specific types of microbial threats.
Key Takeaways
- Flagyl is an antibiotic and antiprotozoal medication used to treat bacterial and parasitic infections.
- It works by damaging the DNA of susceptible microorganisms, preventing their growth and reproduction.
- Common uses include treating bacterial vaginosis, trichomoniasis, giardiasis, and certain anaerobic bacterial infections.
- Potential Flagyl side effects include nausea, headache, and a metallic taste in the mouth.
- Flagyl dosage information varies significantly based on the infection type and patient factors, requiring strict adherence to a healthcare provider’s prescription.
What is Flagyl and How It Works
Flagyl refers to metronidazole, an antimicrobial medication effective against a broad spectrum of anaerobic bacteria and protozoa. It is commonly prescribed for infections where oxygen levels are low, as these are the conditions under which the drug is activated and becomes effective.
How does Flagyl work?
Flagyl works by entering the microbial cell, where it is reduced by specific enzymes found in anaerobic bacteria and protozoa. This reduction process creates highly reactive cytotoxic compounds that damage the microorganism’s DNA and other essential cellular components. This DNA damage inhibits nucleic acid synthesis, ultimately leading to the death of the susceptible bacteria or parasite. This mechanism makes it particularly effective against organisms that thrive in oxygen-depleted environments.
What is Flagyl Used For?
Flagyl is used for treating a range of infections caused by anaerobic bacteria and certain parasites. Its broad-spectrum activity against these specific pathogens makes it a versatile tool in infectious disease management.
Common conditions for which Flagyl is prescribed include:
- Bacterial Vaginosis: A common vaginal infection caused by an overgrowth of certain bacteria.
- Trichomoniasis: A sexually transmitted infection caused by a parasite.
- Giardiasis: An intestinal infection caused by the Giardia lamblia parasite.
- Amebiasis: An infection of the intestines and sometimes other organs caused by the parasite Entamoeba histolytica.
- Clostridioides difficile (C. diff) Infection: A severe diarrheal infection, often acquired in healthcare settings.
- Anaerobic Bacterial Infections: Including those affecting the abdomen, skin, joints, and central nervous system.
According to the Centers for Disease Control and Prevention (CDC), trichomoniasis affects an estimated 3.7 million people in the U.S., highlighting the importance of effective treatments like Flagyl for common parasitic infections.
Flagyl Side Effects and Dosage Information
Like all medications, Flagyl can cause side effects, although not everyone experiences them. Understanding potential reactions and adhering to prescribed regimens are crucial for safe and effective treatment.
Common Flagyl side effects often include nausea, vomiting, diarrhea, abdominal cramps, headache, and a metallic taste in the mouth. More serious, though less common, side effects can include dizziness, numbness or tingling in the extremities (peripheral neuropathy), seizures, and severe allergic reactions. It is critically important to avoid alcohol consumption while taking Flagyl and for at least three days after stopping the medication, as it can lead to a severe disulfiram-like reaction characterized by flushing, headache, nausea, vomiting, and rapid heart rate.
Flagyl dosage information varies significantly depending on the type and severity of the infection, the patient’s age, weight, and overall health. It is available in various forms, including oral tablets, capsules, and intravenous solutions. A healthcare provider will determine the appropriate dose, frequency, and duration of treatment. Patients must complete the full course of medication as prescribed, even if symptoms improve, to ensure the infection is fully eradicated and to prevent the development of antibiotic resistance. Never adjust the dosage or stop the medication without consulting a doctor.